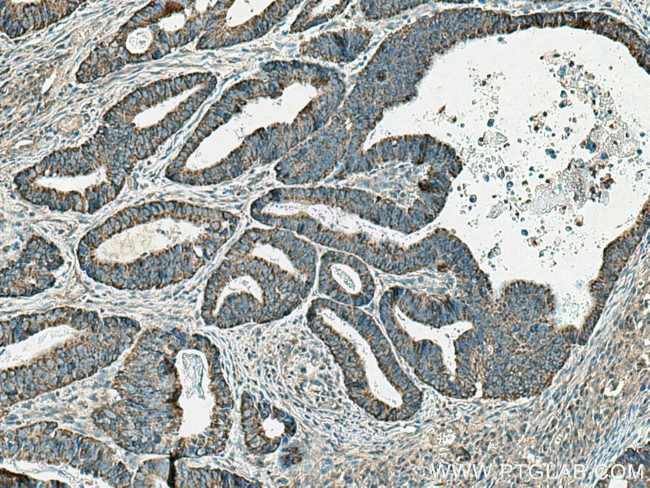
EI24 Antibody in Immunohistochemistry (Paraffin) (IHC (P))

Search
Proteintech
EI24 Polyclonal Antibody
{{$productOrderCtrl.translations['antibody.pdp.commerceCard.promotion.promotions']}}
{{$productOrderCtrl.translations['antibody.pdp.commerceCard.promotion.viewpromo']}}
{{$productOrderCtrl.translations['antibody.pdp.commerceCard.promotion.promocode']}}: {{promo.promoCode}} {{promo.promoTitle}} {{promo.promoDescription}}. {{$productOrderCtrl.translations['antibody.pdp.commerceCard.promotion.learnmore']}}
产品信息
20456-1-AP
种属反应
已发表种属
宿主/亚型
分类
类型
抗原
偶联物
形式
浓度
规格
纯化类型
保存液
内含物
保存条件
运输条件
产品详细信息
Immunogen sequence: SILFPLFII SANEAKTPGK AYLFQLRLFS LVVFLSNRLF HKTVYLQSAL SSSTSAEKFP SPHPSPAKLK ATAGH (267-340 aa encoded by BC002390)
靶标信息
This gene encodes a serine/threonine-protein kinase that functions in cell division. Together with the kinesin KIF14, this protein localizes to the central spindle and midbody, and functions to promote efficient cytokinesis. This protein is involved in central nervous system development. Polymorphisms in this gene are associated with bipolar disorder and risk for schizophrenia. Alternative splicing results in multiple transcript variants.
仅用于科研。不用于诊断过程。未经明确授权不得转售。
生物信息学
蛋白别名: ectopic P-granules autophagy protein 4 homolog; etoposide induced 2.4; Etoposide-induced protein 2.4 homolog; p53-induced gene 8 protein; tumor protein p53 inducible protein 8; unnamed protein product
基因别名: EI24; EPG4; PIG8; TP53I8
UniProt ID: (Human) O14681
Entrez Gene ID: (Human) 9538